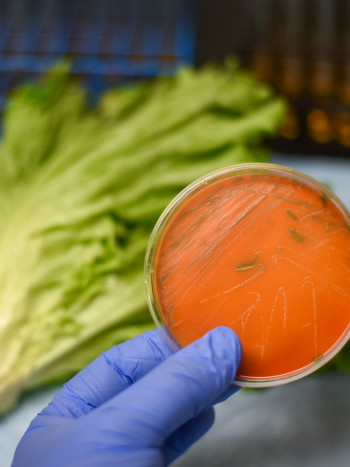
¿Tengo listeriosis? Precauciones MUY importantes para evitar su contagio

Enfermedades

Cuidar de nuestra salud es esencial, más aún cuando sufrimos alguna enfermedad que nos afecta en nuestro día a día. Existen muchas patologías y enfermedades de las que conviene estar bien informadas para actuar de forma preventiva y, sobre todo, para saber qué nos ocurre conociendo nuestro cuerpo a la perfección.
En Diario Femenino te ofrecemos recomendaciones para la prevención y el manejo de diferentes enfermedades, basadas en distintas informaciones y en el conocimiento de especialistas en materia de salud. Consejos prácticos, explicaciones detalladas, síntomas o tratamientos de una gran variedad de enfermedades que te ayudarán a entender y a gestionar tu salud de manera proactiva.